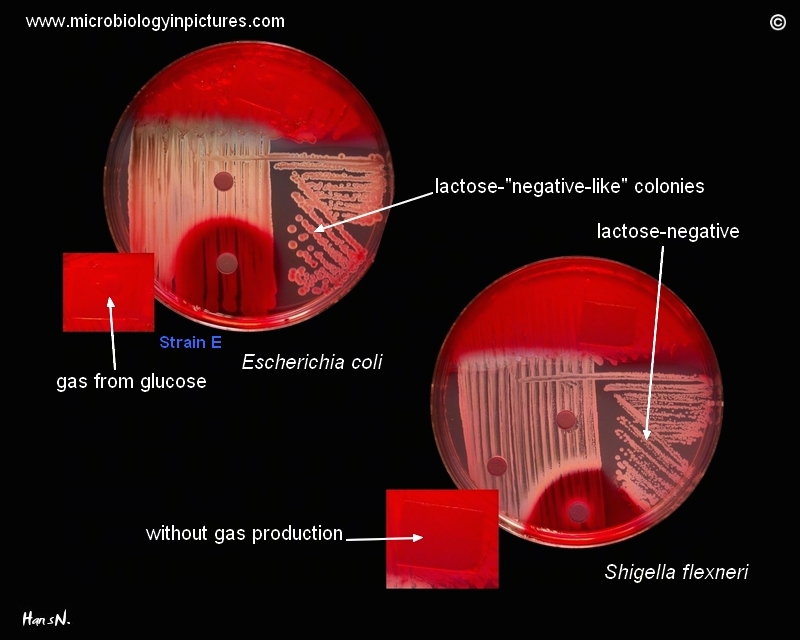

E.coli (the delayed lactose fermenter) can mimic Shigella spp.. Comparison of Escherichia coli and Shigella flexneri. Unlike E.coli are Shigella spp. nonmotile and lysine decarboxylase negative
Cultivation 24 hours, 37°C in an aerobic atmosphere.
General description of testing on Endo agar with biochemical slope is here.
Three Shigella groups are the major disease-causing species: S. flexneri is the most frequently isolated species worldwide, and accounts for 60% of cases in the developing world; S. sonnei causes 77% of cases in the developed world, compared to only 15% of cases in the developing world; and S. dysenteriae is usually the cause of epidemics of dysentery, particularly in confined populations such as refugee camps.
Shigella is one of the leading bacterial causes of diarrhea worldwide. Insufficient data exist, but conservative estimates suggest Shigella causes about 90 million cases of severe dysentery, with at least 100,000 of these resulting in death each year, mostly among children in the developing world.
